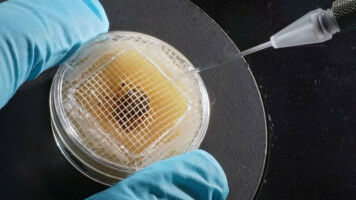
Neues Experiment-Design verbessert Reproduzierbarkeit

news
Friedrich-Schiller-Universität Jena
Ergebnisse 241 - 260 von 306.
Biowissenschaften - 11.08.2020

Forschungsteam aus Jena entschlüsselt komplexes Wechselspiel zwischen Bakterium, Pilz und Pflanze Life Bakterien der Gattung Streptomyces bilden zahlreiche Wirkstoffe, die ihr Überleben in der Natur sichern und dabei helfen, Nahrungskonkurrenten fernzuhalten. So sind die von manchen Streptomyceten gebildeten Azalomycine antimikrobiell aktiv und schädigen auch Zellen höherer Organismen, darunter die Grünalge Chlamydomonas reinhardtii .
Pharmakologie - Gesundheit - 07.08.2020

Bei Katheterbehandlungen mit beschichteten und unbeschichteten Ballons bei Gefäßverschluss am Oberschenkel erweisen sich die Wirkstoffbeschichtungen als Überlegen Es ist die Option für das fortgeschrittene Stadium der Erkrankung: Wenn Medikamente und gezieltes Training die Schmerzen und Beeinträchtigungen durch verengte Beinarterien nicht mehr lindern können, so dass die Betroffenen nach wenigen Schritten stehenbleiben müssen wie bei einem Schaufensterbummel, dann greift der Arzt zum Ballonkatheter.
Chemie - Physik - 05.08.2020

Internationales Forschungsteam entdeckt ungewöhnliche Molekülstrukturen Das Periodensystem kennt 118 chemische Elemente. In unserem Alltag stehen jedoch nur wenige davon im Vordergrund, etwa Wasserstoff, Kohlenstoff, Stickstoff, Sauerstoff und Silizium. Richtig spannend wird es aus chemischer Sicht aber, wenn weniger bekannte Elemente ins Spiel kommen.
Chemie - 31.07.2020

Physiker der Universität Jena an grundlegendem Experiment am CERN beteiligt / Hohe Relevanz für die Tumorbehandlung Light Ein internationales Forschungsteam, an dem auch ein Physiker der Universität Jena beteiligt war, hat zum ersten Mal die sogenannte Elektronenaffinität des chemischen Elements Astat gemessen.
Biowissenschaften - Gesundheit - 24.07.2020

Internationales Forschungsteam klärt genetische Ursache einer spastischen Bewegungsstörung auf Unter der Leitung von Wissenschaftlern aus Jena, Tübingen und München konnte ein internationales Forscherteam Veränderungen im HPDL-Gen als Ursache für eine fortschreitende spastische Bewegungsstörung identifizieren.
Biowissenschaften - Physik - 20.07.2020

Schneller und einfacher zu hochaufgelösten dreidimensionalen elektronenmikroskopischen Bildern von Biomolekülen Light Eine Art Köder, um gezielt Proteinkomplexe aus Mischungen fischen zu können, hat ein interdisziplinäres Team aus Frankfurt/M. und Jena entwickelt. Dank dieses ,,Köders" ist das gewünschte Protein wesentlich schneller für die weitere Untersuchung im Kryo-Elektronenmikroskop (Kryo-EM) verfügbar.
Gesundheit - Biowissenschaften - 03.07.2020

Experten des Universitätsklinikums präsentieren erste Ergebnisse der großen Neustadt-Studie Life "Die gute Nachricht gleich zu Beginn: Wir können die Neustädterinnen und Neustädter beruhigen, wir haben keine Coronaviren mehr nachweisen können", sagt Mathias Pletz, Direktor des Instituts für Infektionsmedizin und Krankenhaushygiene am Uniklinikum Jena (UKJ).
Biowissenschaften - Gesundheit - 12.06.2020

Forschungsteam entdeckt neue Naturstoffe, mit deren Hilfe Mikroben unter Wasser das Wachstum von konkurrierenden Organismen regulieren Life Die schier endlosen Weiten der Ozeane sind lebensfeindliche Wüsten - jedenfalls aus der Perspektive eines im Wasser lebenden Bakteriums. Winzig klein wie es ist, wären seine Chancen äußert gering, in den Wassermassen ausreichend Nahrung zu finden.
Biowissenschaften - 02.06.2020
Internationales Wissenschaftsteam empfiehlt Maßnahmen, um die Reproduzierbarkeit von biomedizinischen Versuchen zu erhöhen Für einige wissenschaftliche Disziplinen, etwa in der Medizin oder der Arzneimittelforschung, sind Experimente mit lebenden Tieren nach wie vor unerlässlich. Wissenschaftlerinnen und Wissenschaftler sind sich ihrer Verantwortung in diesem sensiblen Bereich bewusst und bemüht, die Anzahl der Versuche so gering wie möglich zu halten.
Materialwissenschaft - Chemie - 28.05.2020

Forschungsteam entwickelt neuartige Nano-Schalter, die sich per Lichtsignal bedienen lassen Light Die schematische Illustration zeigt die Wirkungsweise des lichtschaltbarenen Transistors. Die Azobenzol-Moleküle auf der Oberfläche klappen sich durch ultraviolettes Licht (365 nm) bzw. durch blaues Licht (455 nm) in eine jeweils andere Konfiguration.
Biowissenschaften - Chemie - 15.05.2020

Forschungsteam aus Jena, München und New York entwickelt Wirkstoff, der wichtigen Bestandteil des ,,Zellskeletts" mithilfe von Licht kontrolliert Light Life Die Wirkung von Medikamenten mit Licht einund auszuschalten, damit beschäftigt sich die Photopharmakologie. Nun ist es Wissenschaftsteams aus Jena, München und New York erstmals gelungen, auf diesem Weg einen Bestandteil der Zellen zu steuern, der bislang als unerreichbar galt.
Biowissenschaften - Pharmakologie - 11.05.2020

Forschungsteam aus Jena und den USA klärt entzündungshemmende Wirkung eines Naturstoffs aus Weihrauchharz auf Life Ein Forschungsteam der Universität Jena und der Louisiana State University (USA) hat den molekularen Mechanismus der entzündungshemmenden Wirkung eines Naturstoffs aus Weihrauchharz aufgeklärt.
Biowissenschaften - 04.05.2020

Internationales Forschungsteam veranschaulicht, wie sich die Pflanzen in mehr als einer Milliarde Jahren entwickelt haben. Life Es ist das Ergebnis eines Mammutprojekts, das die rund 200 Wissenschaftlerinnen und Wissenschaftler von mehr als 130 Forschungseinrichtungen aus aller Welt heute veröffentlichen.
Biowissenschaften - Gesundheit - 04.05.2020

Bakterien aktivieren Wirkstoffbildung in Pilz / Wirkstoff hindert bakterielle Sporen an Keimung Life Nicht nur Tiere und Pflanzen konkurrieren um Lebensraum: Auch Mikroorganismen besetzen gleiche Habitate und kämpfen um Nahrung. So verhält es sich auch bei dem Bakterium Streptomyces rapamycinicus und dem Pilz Aspergillus fumigatus .
Astronomie & Weltraum - Mathematik - 28.04.2020

Internationales Forschungsteam weist durch aktuelle Beobachtungen die Gültigkeit des "No-Hair"-Theorems nach Light Ein internationales Forschungsteam bestätigt mit Hilfe des Spitzer Weltraumteleskops der NASA, dass es sich bei dem kosmischen Objekt OJ 287 um eine weit entfernte Galaxie handelt, in deren Zentrum sich zwei supermassereiche Schwarze Löcher umkreisen.
Mikrotechnik - Psychologie - 20.03.2020

Psychologieteam untersucht Beziehungen zwischen Mensch und Maschine Eine Welt ohne Roboter ist inzwischen kaum noch vorstellbar. Sie Übernehmen nicht nur wichtige Aufgaben in Produktionsprozessen, immer häufiger kommen sie auch im Dienstleistungssektor zum Einsatz. Als sogenannte android - also menschenähnlich - gestaltete Maschinen unterstützen sie beispielsweise die Betreuung von älteren Menschen.
Psychologie - 11.03.2020

Psychologieteam der Universität Jena untersucht Langlebigkeit von Paarbeziehungen Wahrscheinlich war es noch nie so einfach wie heute, eine Partnerin oder einen Partner zu finden, die oder der zumindest theoretisch auch zu einem passt. Dating-Plattformen im Internet füttern Algorithmen mit Informationen von Suchenden, um für sie das beste Gegenstück zu finden.
Biowissenschaften - Gesundheit - 03.03.2020

Molekularer Schalter in Knochenmarksstammzellen hilft Erforschung von Entzündungsprozessen im Gehirn Life Makrophagen sind als Teil des angeborenen Immunsystems für die Hirnentwicklung und -funktion unablässig. Mit einer neuartigen Methode brachten Wissenschaftler des Universitätsklinikums Jena, der Universität Bonn und des Memorial Sloan Kettering Cancer Center in New York (USA) Makrophagen zum Leuchten, die im Knochenmark gebildet wurden.
Astronomie & Weltraum - Physik - 12.02.2020

Physiker analysieren Gravitationswellensignal GW190425 Light Wenn zwei Neutronensterne miteinander kollidieren, dann bebt sprichwörtlich das All. Ihre Verschmelzung erzeugt Gravitationswellen, die sich in alle Richtungen des Universums ausbreiten und - irgendwann auch auf der Erde messbar sind. So geschehen auch im April des vergangenen Jahres, als die Gravitationswellendetektoren Virgo in Italien und LIGO in den USA das Gravitationswellensignal GW190425 aufzeichneten.
Astronomy / Space Science - Physik - 23.01.2020

Physiker analysieren Gravitationswellensignal GW190425 Wenn zwei Neutronensterne miteinander kollidieren, dann bebt sprichwörtlich das All. Ihre Verschmelzung erzeugt Gravitationswellen, die sich in alle Richtungen des Universums ausbreiten und - irgendwann auch auf der Erde messbar sind. So geschehen auch im April des vergangenen Jahres, als die Gravitationswellendetektoren Virgo in Italien und LIGO in den USA das Gravitationswellensignal GW190425 aufzeichneten.











